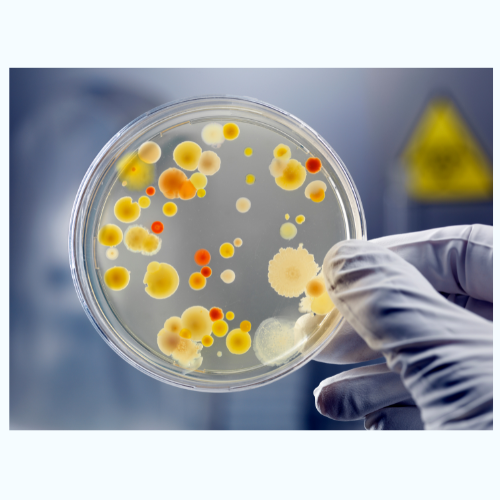

Pourquoi choisir FlowPure ?
Filtration avancée : Élimine plus de 100 contaminants pour une eau pure et sûre.
Goût amélioré : Une eau fraîche, parfaite pour boire et cuisiner.
Installation rapide : Compatible avec tous les robinets, sans outils nécessaires.
Écologique & économique : Réduisez le plastique et faites des économies.
Pourquoi l'eau filtrée est-elle essentielle ?

Filtration Précise
Notre filtre FlowPure se distingue par sa qualité supérieure, avec des matériaux de filtration avancés et un design durable qui garantit l'élimination efficace des contaminants, offrant ainsi l'eau la plus sûre et au meilleur goût possible.


Comment cela fonctionne ?
Grâce à un système de filtration avancé composé de 5 éléments intégrés, ce dispositif élimine efficacement les impuretés de l'eau. Profitez d'une eau pure pour une hydratation optimale au quotidien.
Ils partagent leur expérience

Les pesticides dans l'eau : une menace invisible
L'eau du robinet en France est contaminée par des pesticides, souvent ignorés pour leur toxicité. À Choye, 28 pesticides, dont 13 à des concentrations élevées, ont été détectés. Cela expose la population à des risques sanitaires, nécessitant des travaux pour respecter les normes de qualité de l'eau.

DES MALADIES TERRIBLES
Infections, maladies, troubles du développement chez les enfants, problèmes de santé chroniques et inflammations peuvent tous provenir de la consommation d'eau du robinet non filtrée.

ECZÉMA/ACNÉ
Les produits chimiques présents dans l'eau du robinet non filtrée éliminent les huiles naturelles de votre peau, entraînant sécheresse et irritation. Cela aggrave des affections comme l'eczéma et l'acné, vous laissant avec des démangeaisons et un inconfort constant.

PROBLÈMES DIGESTIFS
Les bactéries peuvent perturber votre estomac, provoquant nausées et diarrhée. Cela empêche votre corps d'absorber les nutriments dont il a besoin, vous laissant épuisé.
Questions fréquemment posées
Qu'est-ce qu'un filtre à eau ?
Un filtre à eau est un processus permettant d'éliminer les particules de l'eau par filtration. Il existe différents types de systèmes de filtration, allant des plus simples aux plus complexes. Certains sont conçus pour éliminer des produits chimiques spécifiques, tandis que d'autres adoptent une approche plus globale. Il est important de connaître les substances présentes dans votre eau pour choisir le filtre le mieux adapté.
Qui devrait utiliser un filtre à eau ?
Un filtre à eau est essentiel pour éviter les effets nuisibles de l'eau fournie aux foyers. Malgré les efforts des gouvernements pour améliorer la qualité de l'eau, des incohérences persistent. L'utilisation de l'eau filtrée présente de nombreux avantages, notamment l'amélioration du goût et de la sécurité, ainsi qu'un meilleur équilibre entre coût et environnement.
Quels types de filtres à eau existent ?
Il existe plusieurs types de filtres à eau, y compris des filtres pour robinet, des filtres pour toute la maison, des filtres sous évier et des carafes filtrantes. Chacun présente des avantages et des inconvénients en fonction de vos besoins, de votre budget et de l'installation.
Quels contaminants peuvent se trouver dans l'eau ?
L'eau peut contenir de nombreux contaminants, tels que le plomb, le chlore et l'arsenic, qui sont dangereux pour la santé. L'exposition prolongée à ces substances peut avoir des effets graves, notamment des troubles neurologiques, des irritations de la peau et un risque accru de cancer. Un filtre à eau comme Flowpure peut protéger votre foyer contre ces contaminants pour un prix abordable.